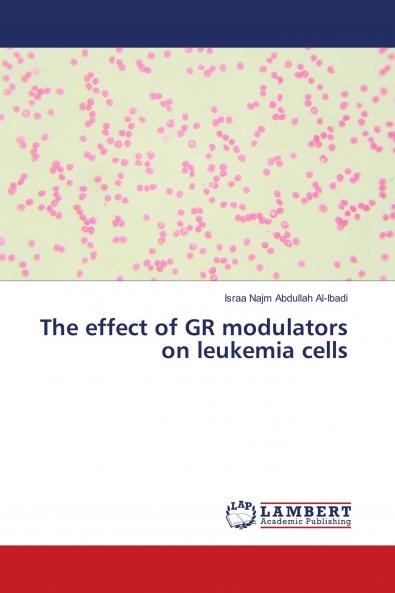
The effect of GR modulators on leukemia cells

English
Paperback
₹8716
(All inclusive*)
Delivery Options
Please enter pincode to check delivery time.
*COD & Shipping Charges may apply on certain items.
Review final details at checkout.
Looking to place a bulk order? SUBMIT DETAILS
Delivery Options
Please enter pincode to check delivery time.
*COD & Shipping Charges may apply on certain items.
Review final details at checkout.
About The Book
Description
Author
Glucocorticoids work through Glucocorticoid receptor to exert their effect. The main effect is anti-allergic and anti-inflammatory. However it prescribed to the patients suffering from leukemia due to its ability to induce apoptosis or programmed cell death (PCD) leaving irreversible side effects. Mainly obesity and mental diturbance .Side effects of Glucocorticoids which have been used for treatment of cancer may be avoided by using another compound which have been tested for its anti-cancer and anti-inflammatory properties and for binding capacity with Glucocorticoid receptor both invivo and insilico
Details
ISBN 13
9786139859078
Publication Date
-16-07-2018
Pages
-272
Weight
-354 grams
Dimensions
-150x220x14.57 mm